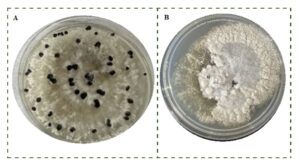

Control biológico:
El potencial de los micovirus para el control de enfermedades de plantas
Autor: María Belia Contreras-Soto
Filiación: Estancias Posdoctorales CONAHCYT. Centro de Investigación en Alimentación y Desarrollo, Subsede Culiacán.
Los hongos causantes de enfermedades en plantas son un problema serio en la agricultura. Combatir estas enfermedades es clave para proteger nuestras cosechas y asegurar que tengamos suficientes alimentos. Pero no podemos simplemente usar productos químicos como antes; ahora se debe pensar en la sostenibilidad y en cuidar el medio ambiente; además que los hongos fitopatógenos se están volviendo más resistentes a los fungicidas. Por lo que, tenemos que encontrar nuevas estrategias con menor impacto ambiental para proteger nuestros cultivos del ataque de los hongos.
Dentro del manejo integrado de las enfermedades causadas por hongos fitopatógenos, se emplean diversas estrategias para combatirlas de manera efectiva y sostenible. Entre estas estrategias se incluye el uso de microorganismos, como hongos y bacterias, o sus metabolitos secundarios bioactivos para el biocontrol, la aplicación de extractos esenciales de plantas y la inducción de hipovirulencia mediante micovirus.
Los micovirus son virus que infectan hongos y han sido estudiados durante más de 70 años en diversos grupos de hongos fitopatógenos. Se transmiten únicamente intracelularmente a través de procesos como la división celular, la esporogénesis y la fusión celular, y su especificidad está restringida a individuos dentro del mismo grupo de compatibilidad vegetativa o grupos estrechamente relacionados.
La hipovirulencia mediada por micovirus es un fenómeno en el que la capacidad de los hongos fitopatógenos para causar enfermedades se reduce como resultado de la infección viral. Esto convierte a los micovirus fitopatógenos en agentes con el potencial de controlar a los hongos causantes de enfermedades en las plantas. Estos virus modifican la fisiología normal de los hongos y alteran sus interacciones con las plantas hospedantes, lo que los convierte en agentes potenciales para el control de enfermedades.
Antecedentes de los micovirus
El origen de los micovirus sigue siendo un misterio, pero se han propuesto dos hipótesis principales:
La primera sugiere una coevolución ancestral a lo largo de millones de años.
La segunda plantea una adaptación más reciente de estos virus, que originalmente infectaban plantas y luego encontraron en los hongos sus nuevos hospedantes.
Aunque comparten algunas características con los virus que afectan a animales y plantas, los micovirus se distinguen por carecer de una vía de infección extracelular y de una proteína de movimiento esencial presente en los virus de animales y plantas.
El primer informe formal de un micovirus data de 1960, cuando se identificaron al menos tres tipos de virus en ejemplares enfermos de champiñón común (Agaricus bisporus). Este acontecimiento marcó el inicio de lo que ahora se conoce como micovirología moderna, un campo dedicado al estudio de estos virus, incluyendo su taxonomía, rango de hospedantes, origen, evolución, transmisión y movimiento.
Los micovirus que inducen la hipovirulencia generalmente infectan a los hongos fitopatógenos y afectan su capacidad para crecer, reproducirse y causar daño a las plantas hospedantes. Uno de los ejemplos más conocidos es el micovirus CHV-1, que causa hipovirulencia en el hongo Cryphonectria parasitica, responsable del chancro del castaño. Este proceso se ha convertido en un área de gran interés para la investigación agrícola, ya que ofrece una alternativa prometedora al control de enfermedades fúngicas en los cultivos.
Mecanismos de transmisión de micovirus
Los micovirus tienen formas especiales de transmitirse entre los hongos. A diferencia de otros virus que afectan a animales y plantas, la mayoría de los micovirus no usan formas externas para infectar, por lo que dependen de vías de transmisión intracelulares. Una de las formas más importantes es cuando los hongos entran en contacto y se fusionan, lo que facilita que los micovirus se pasen de un hongo a otro. También pueden transmitirse a las esporas.
Los micovirus ejercen sus efectos sobre los hospedantes fúngicos a través de una variedad de mecanismos. Algunos micovirus producen infecciones latentes, sin cambios aparentes en la morfología del hongo, llamados virus de naturaleza críptica; mientras que otros inducen hipovirulencia, reduciendo la virulencia del hongo hospedante y ofreciendo un posible mecanismo de control biológico contra las enfermedades en plantas.
Figura 1. Efecto de los hongos con y sin virulencia en las plantas:
A.- Colonia con características morfológicas normales de Sclerotinia sclerotiorum a los 7 días después de incubación en agar dextrosa y papa.
B.- Colonia con un patrón de crecimiento anormal del micelio y baja o nula producción de esclerocios mostrando afectación del hongo por la infección de micovirus.
La interacción entre los micovirus y sus hospedantes fúngicos es dinámica y compleja, determinada por una serie de factores. Los micovirus pueden establecer infecciones persistentes o transitorias en las poblaciones fúngicas, dependiendo de la combinación específica de micovirus y hongo, el estado fisiológico del hospedante y las condiciones ambientales. Factores como la temperatura, la disponibilidad de nutrientes y los factores de estrés pueden influir en el resultado de estas interacciones.
Capacidad de los micovirus para combatir los principales hongos fitopatógenos
La capacidad de los micovirus para controlar los hongos fitopatógenos más importantes se ha investigado ampliamente, mostrando perspectivas alentadoras en el ámbito de la fitopatología. Estos virus se han detectado principalmente en especies de hongos fitopatógenos.
Botrytis cinerea, conocido como el patógeno del moho gris, es especialmente devastador, afectando una amplia gama de cultivos vegetales, frutales y ornamentales. Hasta la fecha, se han identificado al menos 35 especies de micovirus que infectan este hongo.
Fusarium spp., otro fitopatógeno de importancia, causa graves daños en diversos cultivos agrícolas y forestales. Muchos micovirus que infectan especies de Fusarium están en estado latente, pero algunos han demostrado ser hipovirulentos, lo que ofrece perspectivas para el control de enfermedades; dentro de ellos se han reportado al menos 40 micovirus para especies de Fusarium.
Magnaporthe oryzae, responsable de la enfermedad del tizón del arroz, representa una seria amenaza para la producción de arroz a nivel mundial. Dentro de este patógeno, se han identificado más de una docena de micovirus que pueden disminuir su virulencia, ofreciendo posibles enfoques para el control de enfermedades.
Puccinia striiformis, causante de la roya amarilla en el trigo y otros cerealeses un patógeno que se dispersa por el aire y representa una grave amenaza para la seguridad de la producción de trigo a nivel mundial. Se han identificado al menos seis micovirus que causan hipovirulencia, como el Puccinia striiformis mitovirus 1 y el Puccinia striiformis virus 5, que muestran potencial en el manejo de este hongo.
Rhizoctonia solani, un patógeno con origen en el suelo que induce enfermedades como pudrición de raíz y damping-off en varios cultivos. Este hongo fitopatógeno ha sido estudiado en relación con más de 100 virus diferentes, algunos de los cuales han mostrado influencia en el crecimiento y patogenicidad de este hongo.
Sclerotina sclerotiorum, es el principal responsable de la enfermedad conocida como moho blanco, que causa la pudrición del tallo en una amplia variedad de cultivos en distintas condiciones climáticas. Esta enfermedad conlleva a pérdidas significativas en el rendimiento de los cultivos y puede provocar la muerte de las plantas en un tiempo muy corto, a menudo en menos de una semana.
En los últimos años, los micovirus han surgido como una prometedora herramienta de control biológico contra S. sclerotiorum. Estos virus tienen la capacidad de infectar al hongo y reducir su virulencia, alterando su crecimiento e incluso impidiéndole causar enfermedades.

Figura 2. Hipovirulencia mediada por micovirus. (A) Los hongos fitopatógenos representan una amenaza para los cultivos, causando daños significativos y pérdidas económicas, (B) Los micovirus emergen como una opción prometedora de biocontrol, alterando la morfología de los hongos fitopatógenos, lo que afecta el crecimiento, la pigmentación, la esporulación y la virulencia. Se transmiten horizontalmente mediante la fusión de hifas y verticalmente a través de esporas asexuales, promoviendo su expansión en las poblaciones de hongos y contribuyendo a su persistencia; (C) Esta capacidad de control biológico convierte a los micovirus en agentes potenciales para combatir enfermedades fúngicas en cultivos, ofreciendo una alternativa promisoria.
Estudios recientes señalan la existencia de más de 230 micovirus diferentes capaces de infectar a este hongo fitopatógeno.
Consideraciones para aplicar micovirus
Para maximizar la eficacia de los micovirus en el control de enfermedades de plantas, es crucial seleccionar cuidadosamente los micovirus específicos que exhiban las características deseables para combatir los fitopatógenos. Esto implica identificar micovirus con la capacidad de atenuar la patogenicidad o mejorar la resistencia en el hospedante. Además, se deben considerar factores como la estabilidad y compatibilidad del micovirus con el patógeno objetivo. Antes de su aplicación, es esencial caracterizar minuciosamente el micovirus, comprendiendo su genética, estrategia de replicación, hospedantes, persistencia y efectos potenciales en la biología del hospedante.
Determinar el método óptimo para la introducción de micovirus en los suelos de campos agrícolas es crucial. La elección de la forma de aplicación debe adaptarse a las necesidades específicas, considerando tanto el patógeno a controlar como el tipo de cultivo. Por ejemplo, en el caso de la enfermedad del moho blanco, se puede optar por la aplicación a través del agua de riego utilizando aislados hipovirulentos de S. sclerotiorum. Este enfoque asegura el establecimiento de los micovirus y su eficiente transmisión de hongos hipovirulentos a hongos sanos, facilitando así su distribución en el campo. Aunque esta estrategia puede ser efectiva para otros hongos y cultivos, es fundamental adaptar las estrategias de aplicación a cada situación particular.
La hipovirulencia mediada por micovirus es una alternativa que se va a incorporar a las estrategias de manejo de enfermedades actuales, como el control biológico, tratamientos de semillas, y uso de cultivos resistentes. Estas prácticas, junto con la aplicación de fungicidas sistémicos o de contacto, contribuyen a mejorar el control de la enfermedad.
Las pruebas de campo son necesarias para evaluar la eficacia de los micovirus en condiciones realistas, supervisando la severidad de la enfermedad y el rendimiento de los cultivos. Se necesita investigación continua para optimizar los métodos de aplicación, comprender las interacciones con los hospedantes y abordar desafíos como la estabilidad. La colaboración entre investigadores, profesionales de la industria y organismos reguladores es esencial para garantizar el uso seguro y efectivo de los micovirus en la agricultura.

Más historias
Todo listo para el Taller de las Organizaciones de Mango Extranjeras (FMOs) 2026
APEAM y PROFEPA: juntos por el medio ambiente
Asia y Medio Oriente: Dos mercados “muy atractivos” para los Mangos de Michoacán